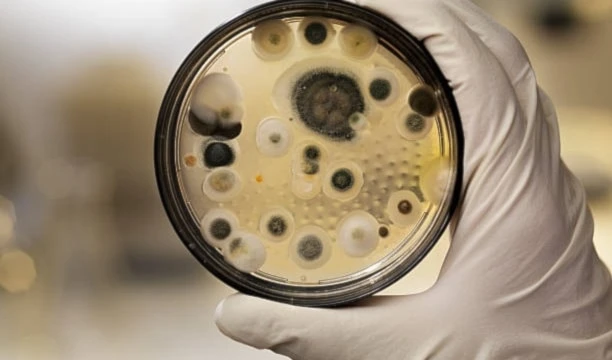

¿Cómo evitar una nueva pandemia cuidando del agua?
El descuido de las aguas residuales podría desencadenar otra crisis sanitaria a nivel global.
-

¿Cómo evitar una nueva pandemia cuidando del agua?
Muchos de los Objetivos de Desarrollo Sostenible (ODS) tienen como fundamento la sostenibilidad del planeta a corto, medio y largo plazo. Entre ellos figura el ODS 6, “Agua y saneamiento”, cuyo mantenimiento es crucial para combatir el hambre, mejorar nuestra salud y para que determinadas regiones puedan completar su desarrollo.
No obstante, no es la única razón de peso para centrar nuestros esfuerzos en cuidar el agua de nuestro planeta. Tras un periodo de crisis sanitaria sobrevenida por la COVID-19, una nueva pandemia podría materializarse a causa de la presencia de antibióticos en las aguas residuales. El Programa de las Naciones Unidas para el Medio Ambiente (PNUMA) ha emitido un informe en abril de este año sobre cómo los patógenos resistentes a los medicamentos presentes en el agua podrían desembocar en una nueva pandemia mundial.
La ONU advierte de que la mayoría de los antibióticos se excretan en el medio ambiente a través de los inodoros o de la defecación al aire libre. Solo en 2015, se consumieron casi 35 mil millones de dosis diarias de antibióticos y hasta el 90 por ciento de ellos se expulsaron al medio ambiente como sustancias activas.
Además, el 80 por ciento de las aguas residuales del mundo no se tratan e incluso en los países del norte global las instalaciones de tratamiento de las mismas no son capaces de filtrar los organismos peligrosos.
¿Cómo se contamina el agua?
La Proceedings of the National Academy of Sciences of the United States of America, también conocida como PNAS, ha publicado otro estudio el 14 de febrero de este mismo año sobre la contaminación de los productos farmacéuticos en los ríos de todo el mundo. En el mismo se concluye que los niveles más altos de patógenos resistentes se encuentran en los países de ingresos bajos y medios y están vinculados a regiones con infraestructuras insuficientes para una correcta gestión de aguas residuales.
En el informe del PNUMA que hemos citado anteriormente, encontramos cinco focos de contaminación que contribuyen a la proliferación y expansión de la resistencia a los antimicrobianos.
Un saneamiento eficiente y la presencia de aguas residuales y desagües, agravado por factores como la defecación al aire libre y el uso excesivo de antibióticos para tratar la diarrea, es el principal factor del empobrecimiento de las aguas residuales.
El resto de fuentes para la contaminación son los efluentes de la fabricación de productos farmacéuticos, los residuos de las instalaciones sanitarias, la utilización de antimicrobianos y estiércoles en la producción de cultivos y, por último, los vertidos de producción animal.
¿Qué podemos hacer para cuidar el agua?
“Los antibióticos y otros fármacos salvan vidas, pero su comportamiento ambiental en el curso de nuestras aguas es importante. Deben utilizarse con cuidado para evitar la resistencia a los antimicrobianos, lo que supone riesgos sociales, medioambientales y financieros para las empresas y para la sociedad en general”, explica la jefa de la Subdivisión de Aguas Marinas y Dulces del PNUMA, Leticia Carvalho.
Frenar la contaminación por antibióticos, mejorar el tratamiento de las aguas residuales y hacer un empleo selecto de los antibióticos es clave para tratar de frenar esta tendencia negativa. El informe solicita optimizar datos y el seguimiento y eliminación de los antimicrobianos, así como que la gobernanza medioambiental y los planes de acciones nacionales se refuercen para limitar la liberación de antimicrobianos.
Si los países limitan la deforestación, que con frecuencia expone a los humanos frente a los animales salvajes portadores de virus y facilita a los patógenos la oportunidad de saltar la especie, se cortará de raíz uno de los grandes peligros de nuestro futuro inmediato.








 Al Mayadeen Español
Al Mayadeen Español